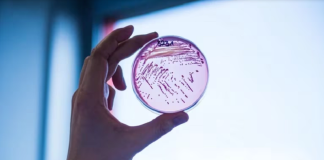
En Argentina se registró un aumento del Síndrome Urémico Hemolítico

Autorizan la vacuna contra el virus que produce la mayor tasa...
ANMAT autorizó la vacuna, ya probada por FDA y EMA, para personas gestantes contra el virus sincicial respiratorio. Las ministras y ministros de todo...
San Martín: aplican con éxito una técnica para enfermedad coronaria
Se llama IVUS y se comenzó a implementar en un hospital público de la Provincia como es el "Eva Perón" de San Martín. El...
Tigre avanza en la obra del nuevo Hospital de Alta Complejidad...
El intendente Julio Zamora supervisó los trabajos en los cuales el Municipio efectúa los primeros 500 metros cuadrados de hormigonado. Una vez culminada la...
Tigre capacitó en RCP a más de 400 trabajadores de empresas...
En el marco del programa "Tigre Cuida tu Corazón", empleados de distintas firmas participaron de la iniciativa del municipio, cuyo objetivo es enseñar mecanismos...
Covid-19: información falsa sobre la variante XBB
El Ministerio de Salud de la Nación advirtió sobre la circulación de información falsa respecto de la variante XBB del virus Sars-Cov-2. Y recuerdó que...
Triquinosis: recomendaciones ante el brote en 9 municipios de la Provincia
A raíz de un brote de triquinosis que ya afectó, al menos, a 118 personas de nueve municipios bonaerenses, el Colegio de Nutricionistas de...
“Lo más importante es entrenar la mente, la parte estética llega...
Así lo afirmó Sergio “Rocky” Hernando, bicampeón argentino y competidor mundialista de culturismo. En la sección “Arranco el Lunes” de Noticias de Salud Radio...
Mes de las infancias: pubertad precoz y la necesidad de superar...
Durante la pandemia se registró un aumneto de la pubertad precoz. Se trata de una condición, marcada por el inicio anticipado de cambios puberales....
Tigre alcanzará un nuevo récord de 1.800.000 atenciones sanitarias en 2023
La proyección del Municipio ronda un incremento de casi el 90% respecto al 2018, mediante una fuerte inversión en los últimos años por parte...
En Argentina se registró un aumento del Síndrome Urémico Hemolítico
En el Día Nacional de la Lucha contra el Síndrome Urémico Hemolítico (SUH), el Colegio de Nutricionistas de la Provincia de Buenos Aires promueve...